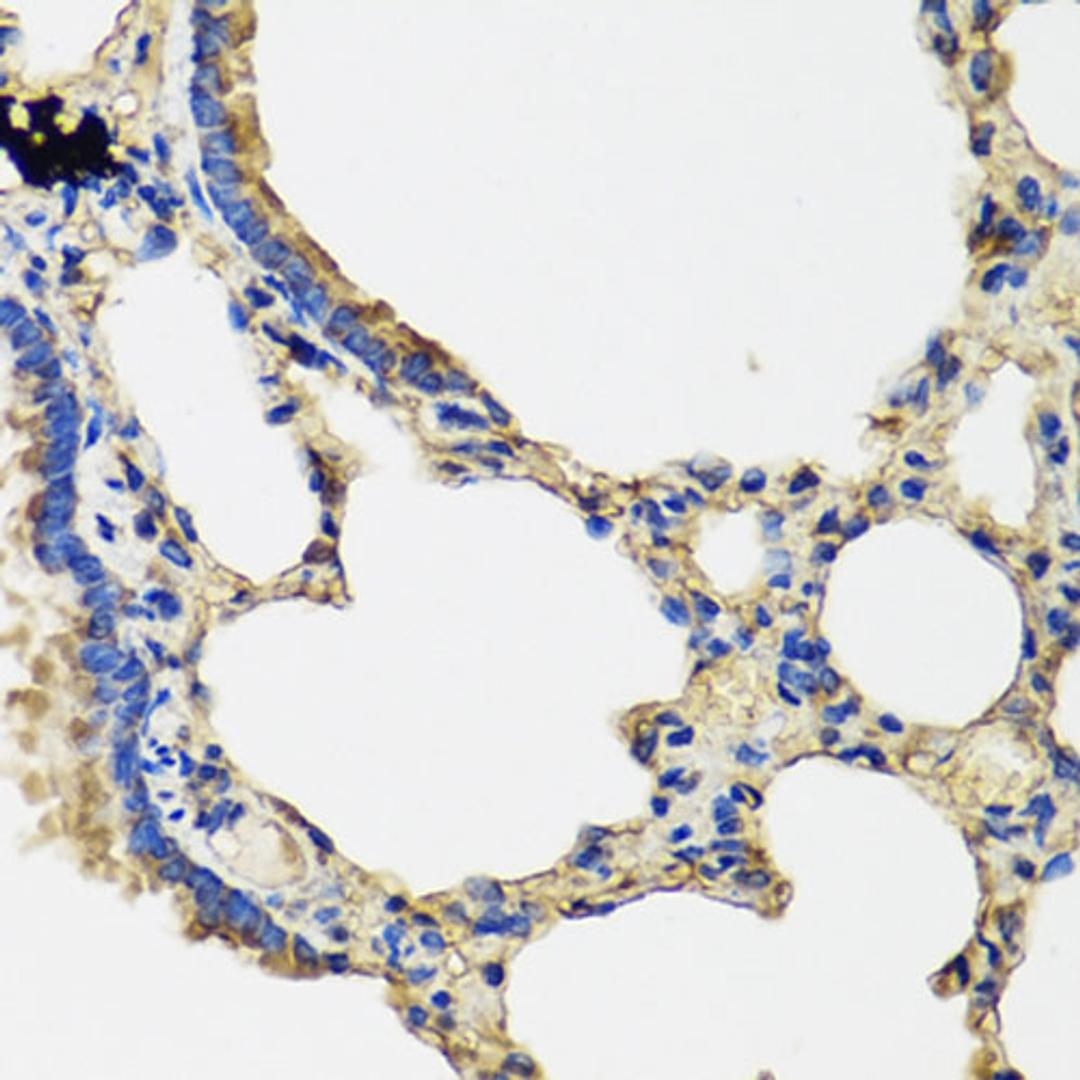
Immunohistochemistry - IL36G antibody (A8304)

IL36G Rabbit pAb
Product Details
- Cat. No.
- A8304
- Type
- Primary Antibody
- Clonality
- Polyclonal
- Host
- Rabbit

The supplier does not provide quotations for this antibody through SelectScience. You can search for similar antibodies in our Antibody Directory.
Description
The protein encoded by this gene is a member of the interleukin 1 cytokine family. The activity of this cytokine is mediated by interleukin 1 receptor-like 2 (IL1RL2/IL1R-rp2), and is specifically inhibited by interleukin 1 family, member 5 (IL1F5/IL-1 delta). Interferon-gamma, tumor necrosis factor-alpha and interleukin 1, beta (IL1B) are reported to stimulate the expression of this cytokine in keratinocytes. The expression of this cytokine in keratinocytes can also be induced by a contact hypersensitivity reaction or herpes simplex virus infection. This gene and eight other interleukin 1 family genes form a cytokine gene cluster on chromosome 2. Two alternatively spliced transcript variants encoding different isoforms have been found for this gene.
Biological Information
- Clonality: Polyclonal
- Host: Rabbit
- Reactivity: Human, Mouse, Rat